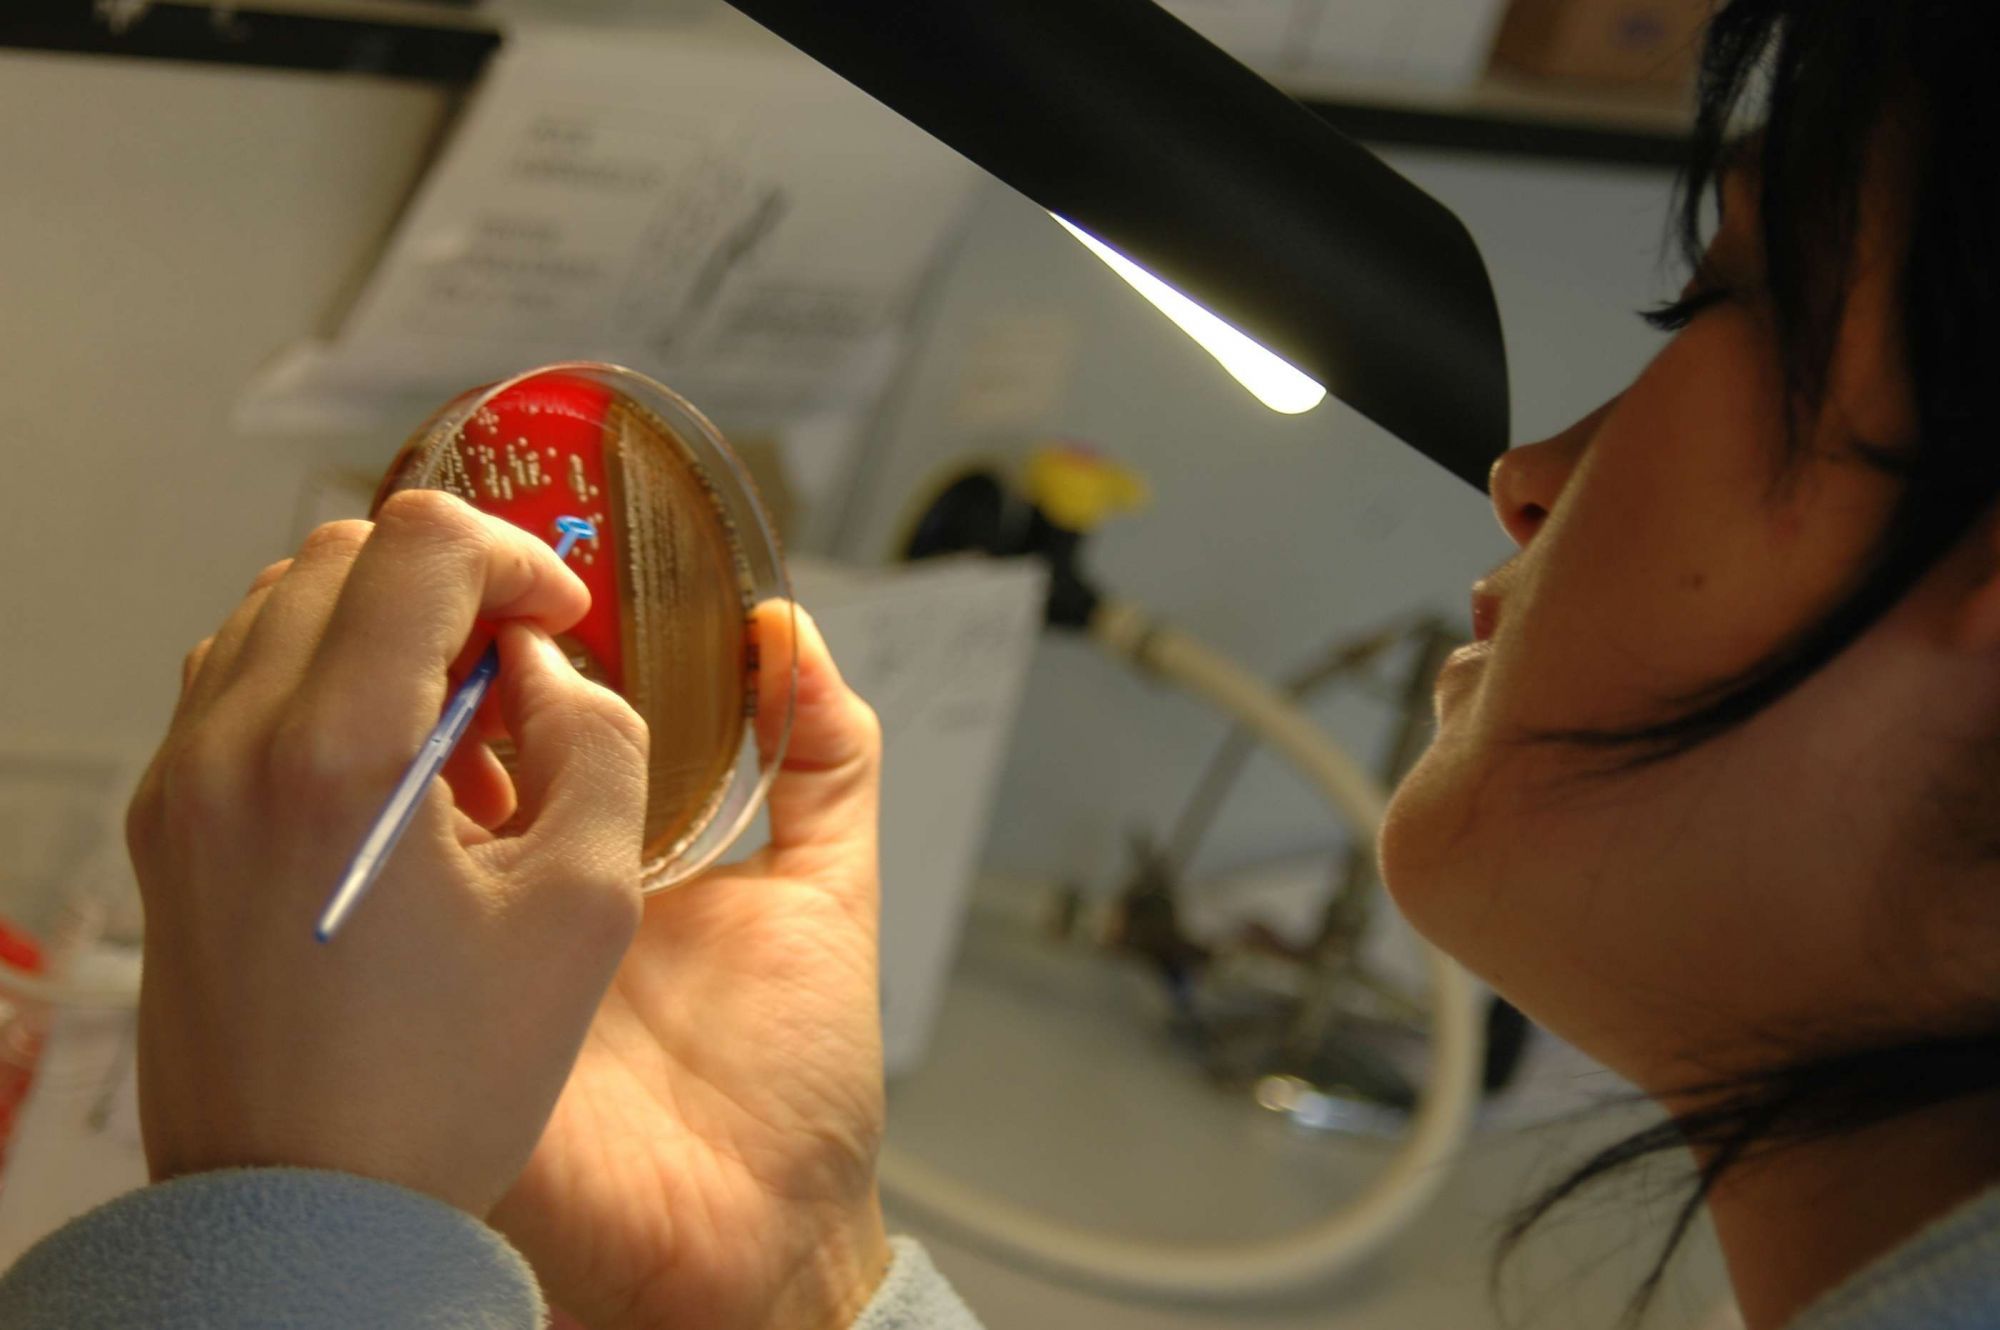

Le financement de la Recherche & de l'Innovation à l'Hôpital Saint Joseph
Les activités de recherche menées à l’Hôpital Saint Joseph bénéficient de financements diversifiés :
- partenariats institutionnels et industriels,
- surcoûts hospitaliers (promoteurs industriels ou institutionnels)
- reversement des honoraires médecins
- subventions industrielles
- financements MERRI*
- appels d’offres
*Les MERRI (Missions d’Enseignement, de Recherche, de Référence et d’Innovation )
L’Hôpital Saint Joseph fait partie des rares établissements hospitaliers privés à but non lucratif à être reconnus par le Ministère des Affaires Sociales et de la Santé au titre des MERRI.
Pour la campagne MERRI 2017, plus de 600 établissements de santé étaient éligibles aux financements MERRI dont seulement 58 établissements privés à but non lucratifs.